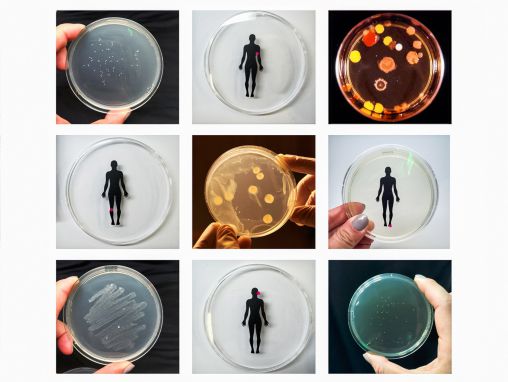

TEDNYC
Todd Scott: Guida intergalattica all'utilizzo di un defibrillatore
Se a Yoda venisse un arresto cardiaco, sapresti cosa fare? Todd Scott, artista e appassionato di primo soccorso, spiega passo passo cosa devi sapere per utilizzare un defibrillatore automatico esterno, o DAE, in questa galassia... e in quelle lontane lontane. Preparati a salvare la vita di uno Jedi, di Chewbacca (che avrà prima bisogno di una rapida rasatura) o qualcun altro a cui serve qualche suggerimento.